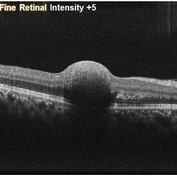
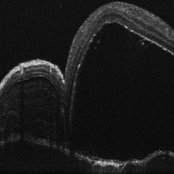

-
 Central Retinal Vein Occlusion with Foveal Hemorrhage
Central Retinal Vein Occlusion with Foveal Hemorrhage
Apr 17 2025 by Malvika Singh
Fundus photograph of a 41 year-old, male, with a central retinal vein occlusion and a foveal sub-internal limiting membrane hemorrhage.
Photographer: Dr Malvika Singh, Retina Foundation, Ahmedabad, India
Imaging device: Mirante SLO/OCT
Condition/keywords: central retinal vein occlusion (CRVO), macular hemorrhage
-
Sub-Internal Limiting Membrane Hemorrhage
Sub-Internal Limiting Membrane Hemorrhage
Apr 17 2025 by Malvika Singh
OCT of a 41 year-old, male, with a central retinal vein occlusion and a foveal sub-internal limiting membrane hemorrhage.
Photographer: Dr Malvika Singh, Retina Foundation, Ahmedabad, India
Imaging device: Mirante SLO/OCT
Condition/keywords: optical coherence tomography (OCT), SUB ILM hemorrhage
-
 Retinitis Pigmentosa with Macular Hole with Posterior Subcapsular Cataract
Retinitis Pigmentosa with Macular Hole with Posterior Subcapsular Cataract
Apr 28 2025 by Malvika Singh
Fundus photograph of the right eye of a 31 year old with retinitis pigmentosa with a macular hole, showing the shadow of posterior subcapsular cataract over the fundus.
Photographer: Dr Malvika Singh, Retina Foundation, Ahmedabad, India
Imaging device: Mirante SLO/OCT
Condition/keywords: macular hole, posterior subcapsular cataract, retinitis pigmentosa
-
 Retinitis Pigmentosa with Macular Hole with Posterior Subcapsular Cataract
Retinitis Pigmentosa with Macular Hole with Posterior Subcapsular Cataract
Apr 28 2025 by Malvika Singh
Fundus photograph of the left eye of a 31 year old with retinitis pigmentosa, showing the shadow of posterior subcapsular cataract over the fundus.
Photographer: Dr Malvika Singh, Retina Foundation, Ahmedabad, India
Imaging device: Mirante SLO/OCT
Condition/keywords: posterior subcapsular cataract, retinitis pigmentosa
-
 A Vessel That Would Not Let Go
A Vessel That Would Not Let Go
May 5 2025 by Malvika Singh
Fundus photograph of a retinal detachment showing a horse shoe shaped tear and a bridging vessel.
Photographer: Dr Tejaswita Verma, Retina Foundation, Ahmedabad, India
Imaging device: Mirante SLO/OCT
Condition/keywords: bridging vessel, horseshoe tear
-
 Circinate Mark at the Macula — a Lasting Trace of Branch Retinal Vein Occlusion
Circinate Mark at the Macula — a Lasting Trace of Branch Retinal Vein Occlusion
May 13 2025 by Malvika Singh
Fundus photograph of a 60 year old with a sclerosed vessel with hard exudates at the macula showing circinate retinopathy after an episode of branch retinal vein occlusion.
Photographer: Dr Malvika Singh, Retina Foundation, Ahmedabad, India
Imaging device: Mirante SLO/OCT
Condition/keywords: branch retinal vein occlusion (BRVO), circinate retinopathy
-
Vogt Kayanagi Harada Disease
Vogt Kayanagi Harada Disease
May 26 2025 by Malvika Singh
OCT image of the retina showing SRF in case of an exudative retinal detachment and bacillary layer detachment
Photographer: Dr Malvika Singh, Retina Foundation, Ahmedabad, India
Imaging device: Mirante SLO/OCT
Condition/keywords: OCT, Vogt-Koyanagi-Harada
-
Central Retinal Artery Pulsations
May 27 2025 by Malvika Singh
Fundus video showing pulsations of the central retinal artery at the excavated optic nerve head.
Condition/keywords: Central retinal artery, Excavated Disc, Fundus Video
-
 Traction in Proliferative Diabetic Retinopathy
Traction in Proliferative Diabetic Retinopathy
Jun 9 2025 by Malvika Singh
Fundus photograph of a 44 year old with uncontrolled diabetes showing fibrovascular proliferation and traction with details of disc and macula obscured with sclerosed vessels in the periphery.
Photographer: Dr Malvika Singh, Retina Foundation, Ahmedabad, India
Imaging device: Mirante SLO/OCT
Condition/keywords: proliferative diabetic retinopathy (PDR), TRACTION
-
 Retinal Detachment with Multiple Horse Shoe Shaped Tears
Retinal Detachment with Multiple Horse Shoe Shaped Tears
Jul 14 2025 by Malvika Singh
Fundus photograph of a 46 year old showing a retinal detachment with multiple peripheral horse show shaped tears.
Photographer: Dr Malvika Singh, Retina Foundation, Ahmedabad, India
Imaging device: Mirante SLO/OCT
Condition/keywords: horseshoe tear, retinal detachment
-
 Branch Retinal Vein Occlusion
Branch Retinal Vein Occlusion
Jul 23 2025 by Malvika Singh
Fluorescein angiogram of a 52 year old man showing capillary non perfusion areas and leakages along the superotemporal arcade and at the macula.
Photographer: Dr Malvika Singh, Retina Foundation, Ahmedabad, India
Imaging device: Mirante SLO/OCT
Condition/keywords: branch retinal vein occlusion (BRVO), CNP areas, macular edema
-
 Jaws of Detachment
Jaws of Detachment
Jul 25 2025 by Malvika Singh
Fundus photograph of a 50 year old with a giant retinal tear and vitreous hemorrhage.
Photographer: Dr Malvika Singh, Retina Foundation, Ahmedabad, India
Imaging device: Mirante SLO/OCT
Condition/keywords: giant retinal tear
-
 A Crack in the Honeycomb
A Crack in the Honeycomb
Jul 28 2025 by Malvika Singh
Fundus photograph of a 44 year old with Doyne's Honeycomb Retinal Dystrophy (autosomal dominant drusen) and a subretinal bleed.
Photographer: Dr Malvika Singh, Retina Foundation, Ahmedabad, India
Imaging device: Mirante SLO/OCT
Condition/keywords: Doyne's Honeycomb, retinal dystrophy, subretinal blood
-
 Ghost Map Retina
Ghost Map Retina
Aug 4 2025 by Malvika Singh
Fundus photograph of a 50 year old male showing extensive chorioretinal scarring.
Photographer: Dr Malvika Singh, Retina Foundation, Ahmedabad, India
Imaging device: Mirante SLO/OCT
Condition/keywords: healed choroiditis
-
 Stars of Stargardt
Stars of Stargardt
Aug 4 2025 by Malvika Singh
Infrared fundus photograph of a 22 year old female with Stargardt's disease.
Photographer: Dr Malvika Singh, Retina Foundation, Ahmedabad, India
Imaging device: Mirante SLO/OCT
Condition/keywords: infrared image, Stargardt disease
-
 Snaking Away
Snaking Away
Sep 1 2025 by Malvika Singh
Fluorescein angiography montage of a 45 year old man showing areas of staining in a case of healed choroiditis.
Photographer: Dr Malvika Singh, Retina Foundation, Ahmedabad, India
Imaging device: Mirante SLO/OCT
Condition/keywords: healed choroiditis, serpiginous choroiditis
-
 Strained Retina
Strained Retina
Sep 27 2025 by Malvika Singh
Fundus photograph of a 44 year old male showing hemorrhages at different layers.
Photographer: Dr Malvika Singh, Retina Foundation, Ahmedabad, India
Imaging device: Mirante SLO/OCT
Condition/keywords: valsalva retinopathy
-
 Strained Retina
Strained Retina
Sep 27 2025 by Malvika Singh
Fundus photograph of a 44 year old male showing hemorrhages at different layers.
Photographer: Dr Malvika Singh, Retina Foundation, Ahmedabad, India
Imaging device: Mirante SLO/OCT
Condition/keywords: valsalva retinopathy
-
 Serous River of Light
Serous River of Light
Sep 30 2025 by Malvika Singh
Fundus autofluorescence of a 55 year old man with history of chronic central serous chorioretinopathy showing an old gravitational track.
Photographer: Dr Malvika Singh, Retina Foundation, Ahmedabad, India
Imaging device: Mirante SLO/OCT
Condition/keywords: central serous retinopathy (CSR)
-
 Folded Macula
Folded Macula
Oct 13 2025 by Malvika Singh
Fundus photograph of a 25 year old male showing retinal detachment with macula off with retinal folds at the macula.
Photographer: Dr Malvika Singh, Retina Foundation, Ahmedabad, India
Imaging device: Mirante SLO/OCT
Condition/keywords: retinal detachment
-
 Multilayer Trauma
Multilayer Trauma
Nov 3 2025 by Malvika Singh
Fundus photograph of a 34 year old following trauma showing a choroidal rupture, a sub RPE and sub retinal bleed.
Photographer: Dr Malvika Singh, Retina Foundation, Ahmedabad, India
Imaging device: Mirante SLO/OCT
Condition/keywords: Choroidal Rupture, subretinal hemorrhage
-
 Optic Disc Drusen in Rod Cone Dystrophy
Optic Disc Drusen in Rod Cone Dystrophy
Nov 3 2025 by Malvika Singh
Fundus autofluorescence of a 22 year old male with rod cone dystrophy with hyperautofluorescent disc drusen.
Photographer: Dr Malvika Singh, Retina Foundation, Ahmedabad, India
Imaging device: Mirante SLO/OCT
Condition/keywords: optic disc drusen, Rod cone dystrophy
-
 Filigree Networks
Filigree Networks
Nov 14 2025 by Malvika Singh
Fundus photograph of a 31 year old male with type 1 diabetes mellitus showing neovascularisation along the superotemporal arcade.
Photographer: Dr Malvika Singh, Retina Foundation, Ahmedabad, India
Imaging device: Mirante SLO/OCT
Condition/keywords: neovascularization (NV), proliferative diabetic retinopathy (PDR)
-
 The Bonus Vessel's Betrayal
The Bonus Vessel's Betrayal
Dec 8 2025 by Malvika Singh
Fundus photograph of a healthy 46 year old male with cilioretinal artery occlusion, macular ischemia and cherry red spot with normal surrounding retina.
Photographer: Malvika Singh
Imaging device: Mirante SLO Imaging Device
Condition/keywords: cilioretinal artery occlusion
-
 Layered Echoes of a Lost Lens
Layered Echoes of a Lost Lens
Dec 16 2025 by Malvika Singh
B scan of a 31 year old male, showing a dislocated crystalline lens in the vitreous.
Photographer: Malvika Singh
Condition/keywords: dislocated crystalline lens
-
Unanchored
Dec 16 2025 by Malvika Singh
Dynamic B-scan showing free movements of the dislocated lens in the vitreous cavity post trauma.
Condition/keywords: dislocated lens
-
The B-scan Ballet
Dec 16 2025 by Malvika Singh
Dynamic B-scan showing post-traumatic dislocated lens in the vitreous, freely moving in the cavity with eye movements.
Condition/keywords: dislocated lens

A project from the American Society of Retina Specialists